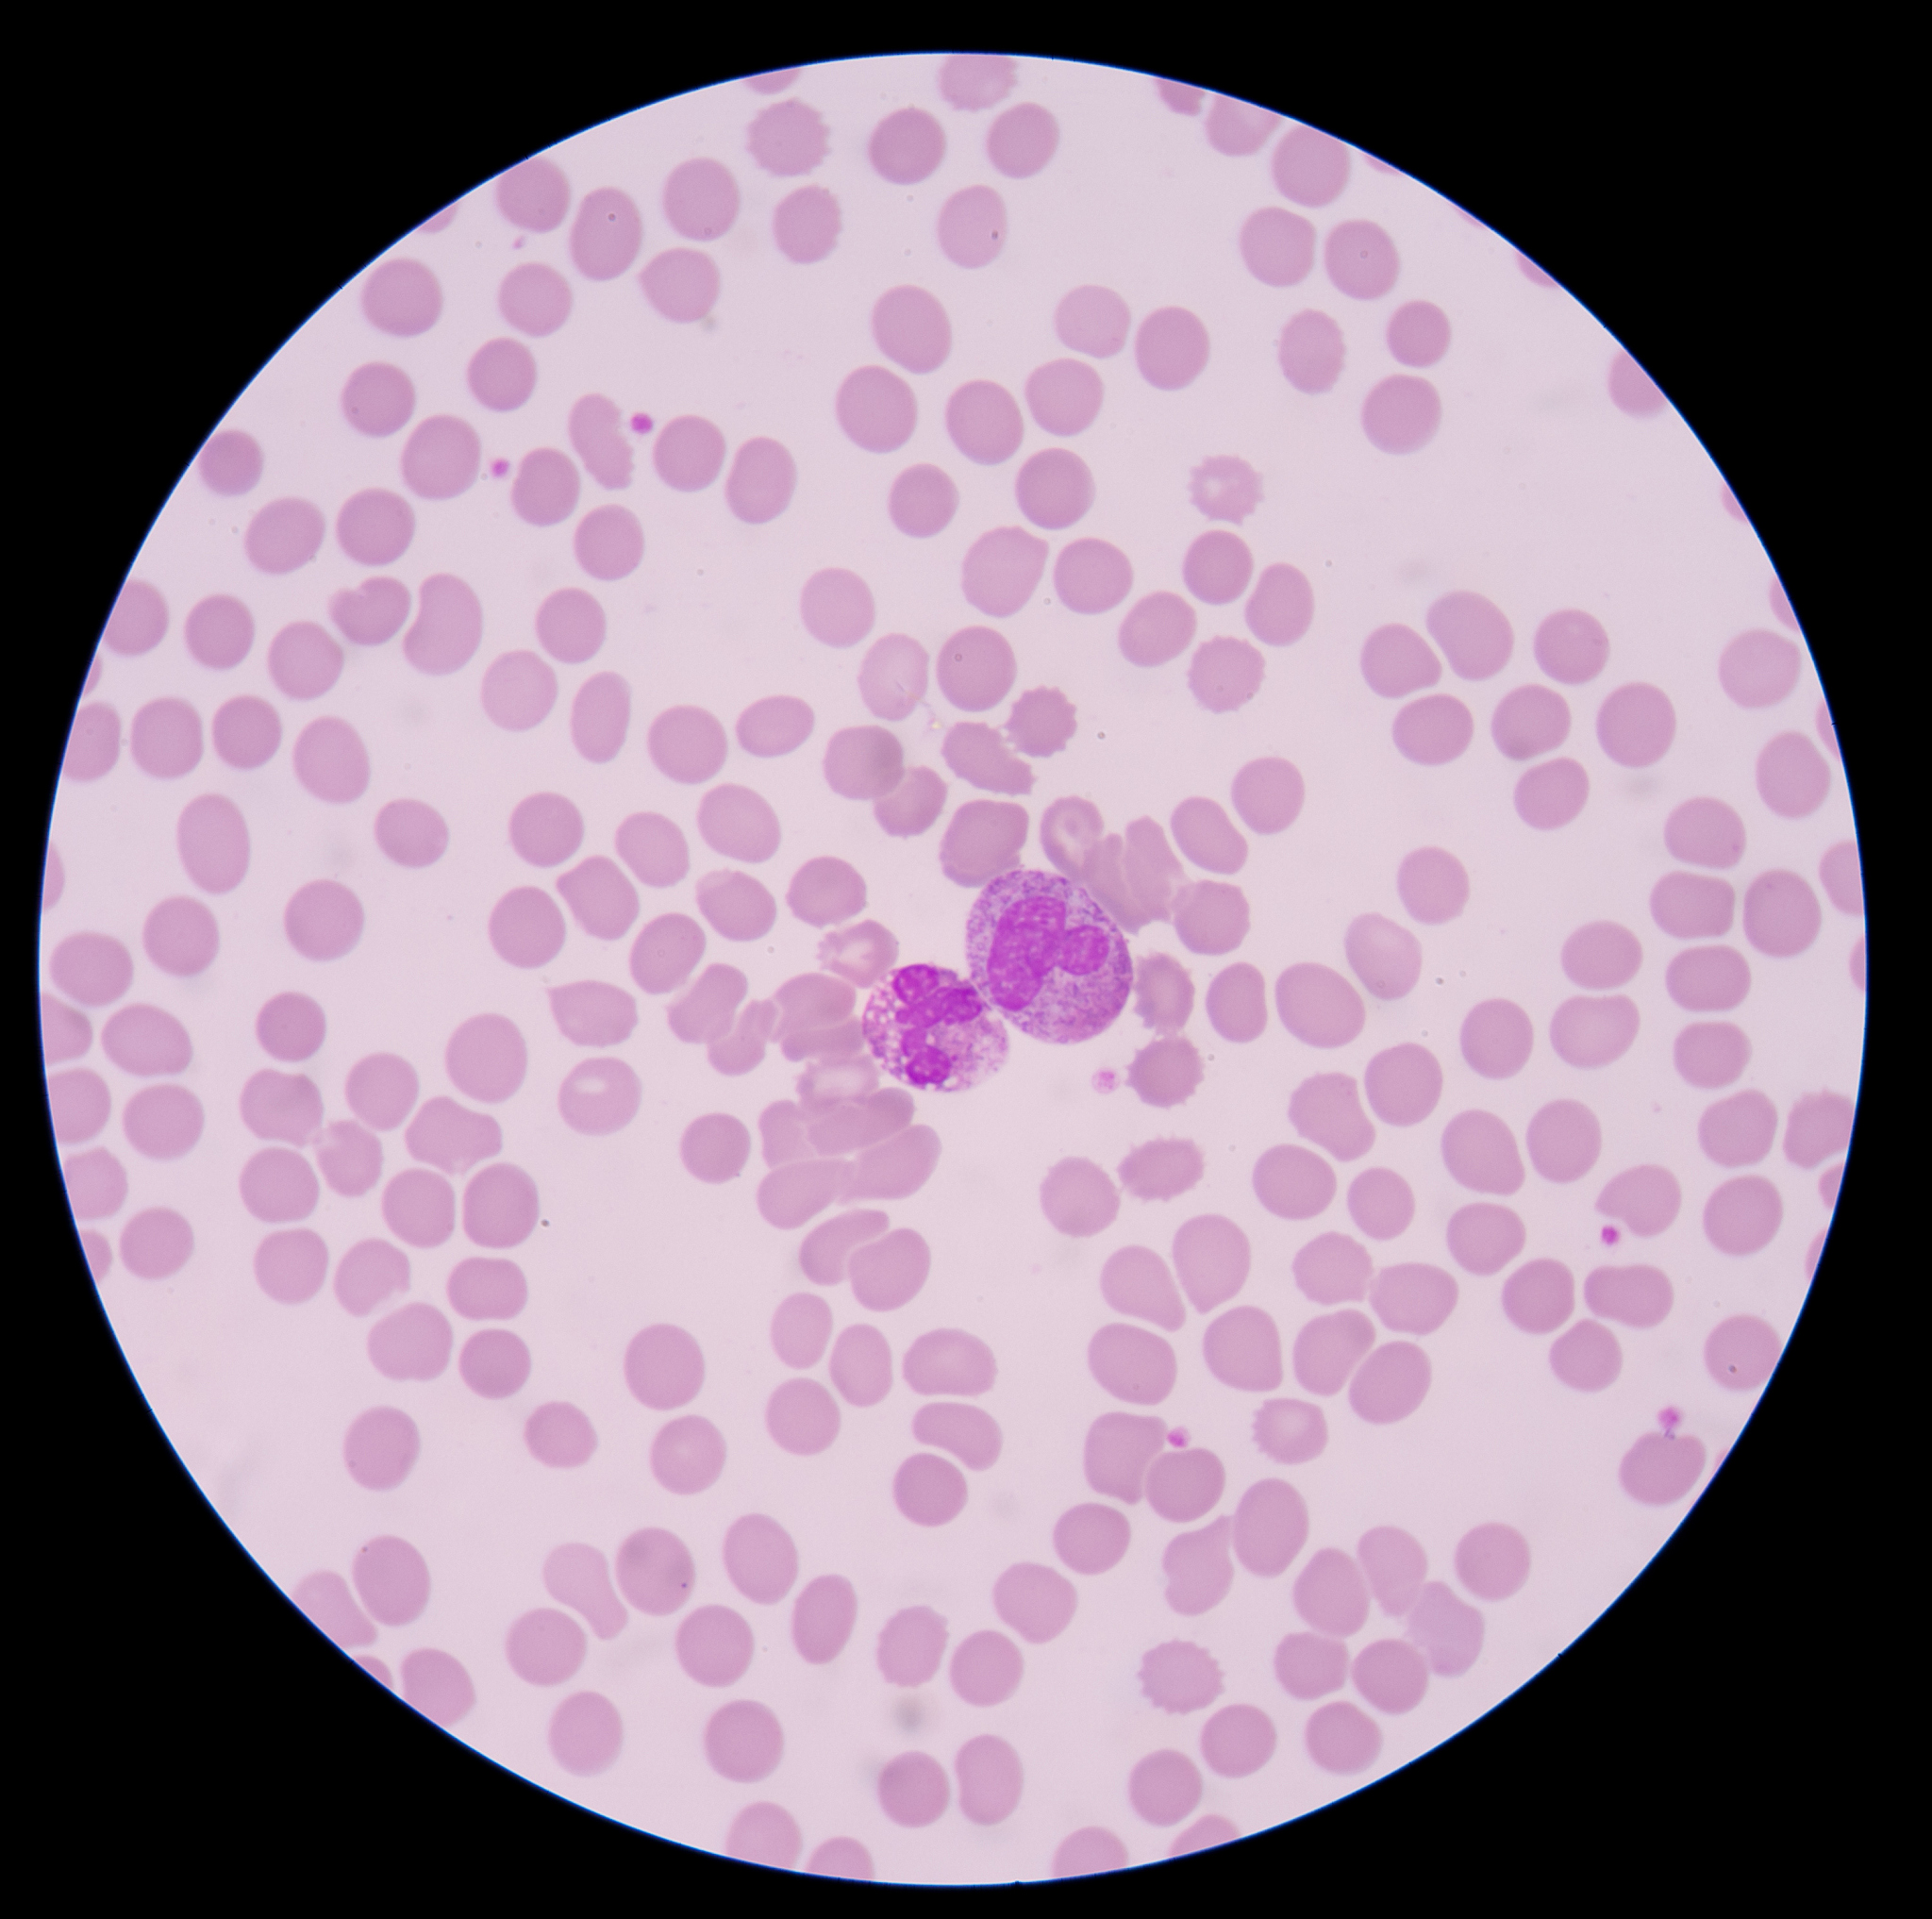
脓毒症和败血症区别

脓毒症和败血症区别
脓毒症和败血症都是严重的感染疾病,但它们之间存在一些区别:
-
发病机制不同:脓毒症是由于感染引起的全身炎症反应,而败血症则是由于血液中存在大量细菌或其代谢产物导致的全身炎症反应。
-
症状不同:脓毒症的症状包括高热、寒战、心率加快、呼吸急促、皮肤潮红等,而败血症的症状包括高热、寒战、低血压、心率加快、皮肤苍白等。
-
感染部位不同:脓毒症通常是局部感染引起的,如皮肤感染、呼吸道感染等,而败血症则可以由全身感染引起,如泌尿系感染、肠道感染等。
-
治疗方法不同:脓毒症和败血症的治疗方法也不完全相同,治疗脓毒症通常采用抗生素、炎症抑制剂等药物,而败血症的治疗则需要对病原体进行针对性治疗,并需要积极支持治疗,如输液、氧疗等。
综上所述,脓毒症和败血症虽然都是全身炎症反应引起的严重感染疾病,但它们之间存在一些不同之处,因此在临床上需要根据具体情况进行区分和治疗。
原文地址: https://www.cveoy.top/t/topic/fjDh 著作权归作者所有。请勿转载和采集!